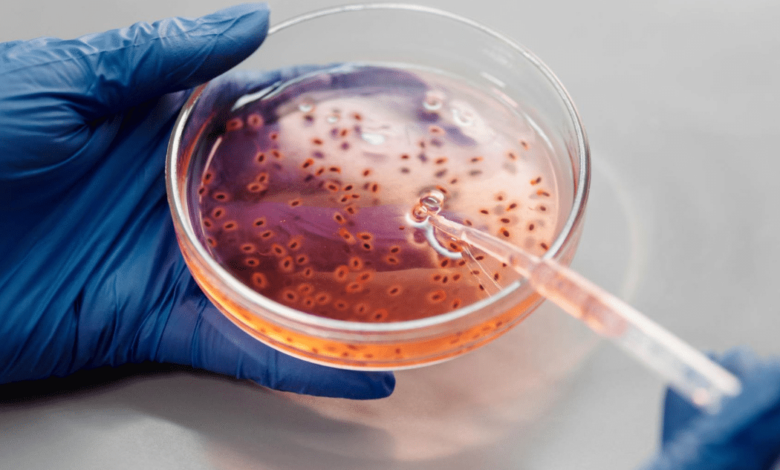

El titular de la Secretaría de Salud, Vicente Joel Hernández Navarro, señaló que ante la detección de la bacteria Klebsiella oxytoca en algunos estados del país, las autoridades sanitarias de Tamaulipas se encuentran en estado de alerta y mantienen la revisión de insumos y medicamentos que circulan en el estado para evitar que ingresen productos contaminados.
Esto lo dijo luego de descartar la presencia de la bacteria y confirmar que la federación emitió la alerta sanitaria para verificar que los productos médicos de las unidades hospitalarias no representan un riesgo para la salud de la población.
“En Tamaulipas no tenemos esta situación, pero estamos en constante revisión y somos cuidadosos con cualquier producto o cuando hay un lote de donación se pasa a la COEPRIS para que verifique las condiciones y que sea un medicamento registrado; y a la fecha se descarta la presencia de esta bacteria”, expresó Hernández.
Dijo que se trabaja sobre el uso y abuso de los antibióticos, debido a que generan resistencia y esto es lo que ha provocado que la bacteria Klebsiella sea difícil de eliminar y aunque el gobernador Américo Villarreal Anaya ha gestionado para contar con todos los niveles de antibióticos, la idea es no abusar de ellos.
Ante tal situación, se estima que los nuevos casos registrados de Klibsiella, se da por una situación de contaminación y se generó una resistencia que necesita antibióticos más potentes para poder actuar, además que provoca una infección grave que puede causar la muerte.
El funcionario estatal señaló que la presencia de la bacteria está relacionada con la marca de algún producto y para ello se deben hacer investigaciones para determinar cuál es la causante y cuál es el vehículo que llegó a contaminarlo.